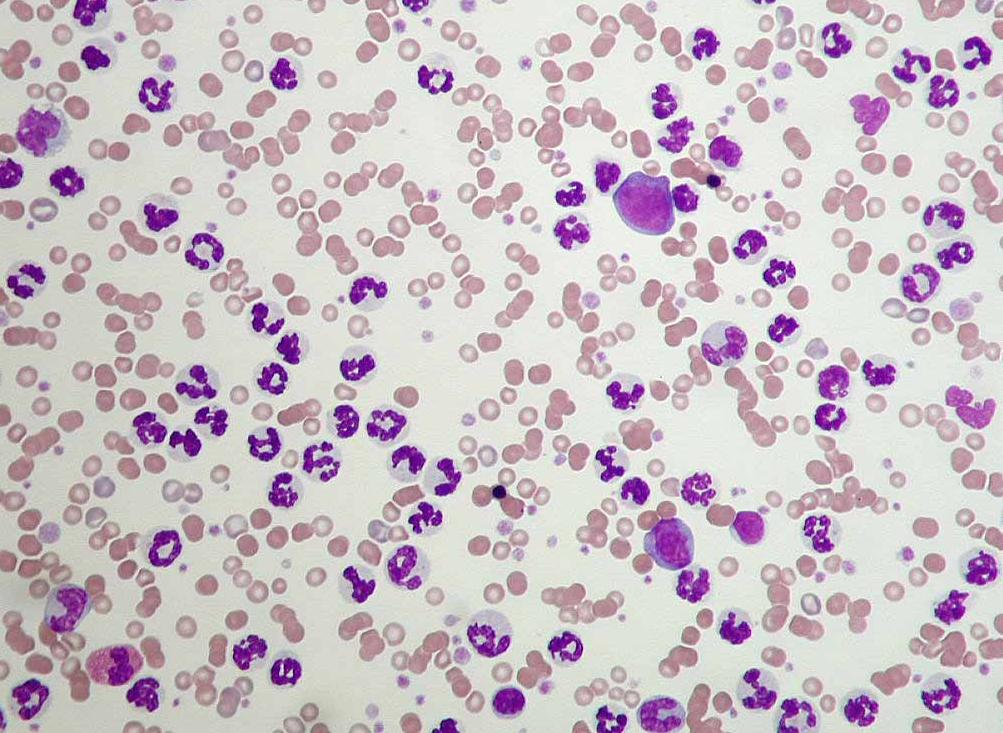

Другие названия и синонимы
Leukocytosis, Увеличение лейкоцитов в крови, повышение числа лейкоцитов в крови, лейкоциты крови выше нормы.
Описание
Лейкоцитоз - повышение уровня лейкоцитов крови выше нормы.
Их активность в периферической крови увеличивается из-за появления инфекционных агентов. Во многих случаях лейкоцитоз является защитной реакцией и важным признаком в диагностике множества заболеваний.
Их активность в периферической крови увеличивается из-за появления инфекционных агентов. Во многих случаях лейкоцитоз является защитной реакцией и важным признаком в диагностике множества заболеваний.
|
|
Нормальные значения
У взрослых и детей уровень лейкоцитов отличается. У взрослых количество лейкоцитов считается в норме 9,0?10/л, у детей 32,0?10/л, а в возрасте 7 лет 11,0?10/л.
Дополнительные факты
Клеточный и гуморальный иммунитет формируется при помощи лейкоцитов, благодаря чему образуется защитная функция. Они способны растворить повреждённую ткань и осуществить гистолическую задачу, а в эмбриональном периоде уничтожать закладки.
Абсолютный лейкоцитоз обуславливается повышенной продукцией лейкоцитов. Больных, находящихся в агональнальном состоянии, сопровождает агональный лейкоцитоз.
Местный лейкоцитоз сопровождается перераспределением лейкоцитов на определённом участке сосудистого русла.
Интенсивная мышечная работа сопровождается миогенным лейкоцитозом.
При переходе в вертикальное положение из горизонтального, возникнет ортостатический лейкоцитоз.
Переход белых кровяных телец из депо в кровеносное русло сопровождается перераспределительным лейкоцитозом.
При введении адреналина в организм возникает постадреналиновый лейкоцитоз.
При сильном эмоциональном потрясении возникает эмоциогенный лейкоцитоз.
В состав лейкоцитов входят следующие ферменты: протеазы, диастазы, липазы, пептидазы, находящиеся в спокойном состоянии. Размеры лейкоцитов от 7 до 20 мкм. Свою функцию они выполняют за границами сосудов, сосудистое русло им необходимо с целью возможности передвижения. Также для них характерно амебовидное движение, благодаря которому им удаётся проникнуть через капиллярный эндотелий, направляясь к поражённому участку. Отрицательный хемотоксин - обратное движение лейкоцитов. Их средняя продолжительность жизни может достигать 20 лет.
Основными задачами лейкоцитов является формирование гуморального и клеточного иммунитета, осуществление гистологической и морфогенной функции.
Абсолютный лейкоцитоз обуславливается повышенной продукцией лейкоцитов. Больных, находящихся в агональнальном состоянии, сопровождает агональный лейкоцитоз.
Местный лейкоцитоз сопровождается перераспределением лейкоцитов на определённом участке сосудистого русла.
Интенсивная мышечная работа сопровождается миогенным лейкоцитозом.
При переходе в вертикальное положение из горизонтального, возникнет ортостатический лейкоцитоз.
Переход белых кровяных телец из депо в кровеносное русло сопровождается перераспределительным лейкоцитозом.
При введении адреналина в организм возникает постадреналиновый лейкоцитоз.
При сильном эмоциональном потрясении возникает эмоциогенный лейкоцитоз.
В состав лейкоцитов входят следующие ферменты: протеазы, диастазы, липазы, пептидазы, находящиеся в спокойном состоянии. Размеры лейкоцитов от 7 до 20 мкм. Свою функцию они выполняют за границами сосудов, сосудистое русло им необходимо с целью возможности передвижения. Также для них характерно амебовидное движение, благодаря которому им удаётся проникнуть через капиллярный эндотелий, направляясь к поражённому участку. Отрицательный хемотоксин - обратное движение лейкоцитов. Их средняя продолжительность жизни может достигать 20 лет.
Основными задачами лейкоцитов является формирование гуморального и клеточного иммунитета, осуществление гистологической и морфогенной функции.
Классификация
Лейкоцитоз по природному происхождению можно разделить на экзогенный и эндогенный. Причины его возникновения могут быть физическими (воздействие ионизирующей радиации на организм), химическими (пониженный уровень кислорода в воздухе, алкоголь, приём препаратов, стимулирующие клеточное разрастание), биологическими (повышенный уровень лейкопоэза и гистамина, элементы погибших вирусов, бактерий).
Причины
Причины возникновения лейкоцитоза самые разнообразные:
- Появление любого острого инфекционного процесса: чума, ОРВИ, холера, грипп провоцируют заболевание, так как начинают реагировать иммунокомпетентные клетки;
- В случае хронического воспалительного заболевания любого органа. Однако проявление лейкоцитоза будет менее выраженным из-за того, что организм привыкает, а не борется;
- В случае травмированных тканей, так как кровяные тельца устремятся в необходимое место;
- При приёме пищи уровень будет повышен, так как лейкоциты будут поступать в циркуляцию крови из депо, и начнут скапливаться в подслизистой части кишечника. Несмотря на то, что процесс является физиологическим, перед сдачей крови нельзя принимать пищу, иначе это может врача ввести в заблуждение;
- При наличии аутоиммунных заболеваний, так как организм постоянно борется. По этой причине не следует проводить анализ, если присутствует явная аллергическая реакция. Возникает эозофильный лейкоцитоз, который сопровождается ускоренным образованием или выходом в кровь эозофилов. Как правило, заболевание не наблюдается у здоровых людей, однако, довольно часто встречается при вакцинации, синдроме Леффлера, скарлатине, дерматозах, глистных инвазиях, отёке Квинке, лимфогранулематозе, миелоидном лейкозе, бронхиальной астме, эозофильных лёгочных инфильтратах, лёгочном периартериите;
- При физической и психоэмоциональной нагрузках, в которых белые кровяные клетки также принимают участие;
- При поступлении лекарственных препаратов в организм, кровяные клетки реагируют на них как на инородные тела и усиленно размножаются;
- В отличие от взрослых, лейкоцитоз чаще возникает у детей, так как к вышеперечисленным факторам надо учесть, что организм в детском возрасте реагирует чаще и быстрее на различные воздействия. Бег, подвижные игры, физическая нагрузка провоцируют повышение белых кровяных клеток. Они выполняют метаболическую функцию у новорождённых, и их высокий уровень будет весьма настораживающим;
- Во время беременности белые кровяные клетки защищают женщину и ребёнка, поэтому высокий уровень является физиологическим процессом. Однако, возможно, образование базофильного лейкоцитоза, при котором увеличивается образование базофилов. Белые кровяные тельца также стимулируют сократительную маточную функцию и предупреждают попадание инфекций;
- Формула лейкоцитов у мужчин стабильная в случае отсутствия занятий силовыми видами спорта, интенсивных мышечных работах. Эти факторы являются основной причиной высокого лейкоцитоза;
- Нарушенный лейкопоэз в костном мозге не связан с физиологическим воздействием, а является подтверждением наличия заболевания.
Физиологический лейкоцитоз обуславливается перераспределением в сосуды разных органов увеличенного количества белых клеток. Как правило, возникает во время беременности, родов, предменструального периода, приёма пищи, холодных и горячих ванн, физической работы. Также в течение дня курение способствует повышенному уровню лейкоцитов.
Патологическое возникновение лейкоцитоза весьма опасно и связано с такими заболеваниями, как пиелонефрит, пневмония, менингит, сепсис и многие другие. А также в связи с заболеваниями, поражающими клетки иммунной системы и вызывающими воспалительный процесс. Исключениями будут заболевания, которые протекают с лейкопенией (краснуха, брюшной тиф, вирусный гепатит, корь, бруцеллёз, малярия в острой фазе). Высокий лейкоцитоз свидетельствует о борьбе организма, в обратном случае это будет свидетельствовать о неблагоприятном исходе.
Также развитие лейкоцитоза провоцируют воспалительные процессы немикробной этиологии, различные инфаркты, в основе которых лежит асептическое воспаление, кровопотери, ожоги, злокачественные образования. Исключением будут лишь метастазы в костном мозге, вследствие чего нарушается кроветворение и образуется лейкопения. Также уремия, диабетическая кома и удалённая селезёнка способствуют развитию патологической формы заболевания.
Кратковременный лейкоцитоз может возникнуть в процессе выброса лейкоцитов в кровь (стресс, переохлаждение). Реактивный лейкоцитоз может исчезнуть вместе с причиной его образования.
При наличии неспецифического язвенного колита, микседемы, хронического миелоидного лейкоза и беременности, довольно часто встречается базофильный лейкоцитоз, однако, это редкий клинико-гематологический синдром. При наличии хронической формы миелолейкоза, повышенный уровень базофилов свидетельствует о неблагоприятных признаках.
При наличии коклюша, вирусного гепатита, инфекционного мононуклеоза, туберкулёза, саркоидоза, сифилиса и других специфических инфекций, обнаруживается лимфоцитарный лейкоцитоз. Его механизм действия полностью неизвестен. Повышенное количество лимфоцитов, которые определяются по лейкоцитограмме, являются неистинными, а относительными и связаны с лейкопенией.
О начале септического процесса будет свидетельствовать моноцитарный лейкоцитоз. Как правило, это форма проявляется у пациентов имеющих туберкулёз, бруцеллёз, малярию, сыпной тиф, рак яичников и молочной железы, саркоидоз, инфекционный мононуклеоз, системное заболевание соединительной ткани, септический эндокардит.
Наблюдается повышенный уровень моноцитов у больных с агранулоцитозом на этапе выздоровления. Стабильно повышенный уровень моноцитов характерен при моноцитарном и миеломоноцитарном лейкозе. При наличии агранулоцитоза, повышение моноцитов будет свидетельствовать о начале регенерации кровотечения.
- Появление любого острого инфекционного процесса: чума, ОРВИ, холера, грипп провоцируют заболевание, так как начинают реагировать иммунокомпетентные клетки;
- В случае хронического воспалительного заболевания любого органа. Однако проявление лейкоцитоза будет менее выраженным из-за того, что организм привыкает, а не борется;
- В случае травмированных тканей, так как кровяные тельца устремятся в необходимое место;
- При приёме пищи уровень будет повышен, так как лейкоциты будут поступать в циркуляцию крови из депо, и начнут скапливаться в подслизистой части кишечника. Несмотря на то, что процесс является физиологическим, перед сдачей крови нельзя принимать пищу, иначе это может врача ввести в заблуждение;
- При наличии аутоиммунных заболеваний, так как организм постоянно борется. По этой причине не следует проводить анализ, если присутствует явная аллергическая реакция. Возникает эозофильный лейкоцитоз, который сопровождается ускоренным образованием или выходом в кровь эозофилов. Как правило, заболевание не наблюдается у здоровых людей, однако, довольно часто встречается при вакцинации, синдроме Леффлера, скарлатине, дерматозах, глистных инвазиях, отёке Квинке, лимфогранулематозе, миелоидном лейкозе, бронхиальной астме, эозофильных лёгочных инфильтратах, лёгочном периартериите;
- При физической и психоэмоциональной нагрузках, в которых белые кровяные клетки также принимают участие;
- При поступлении лекарственных препаратов в организм, кровяные клетки реагируют на них как на инородные тела и усиленно размножаются;
- В отличие от взрослых, лейкоцитоз чаще возникает у детей, так как к вышеперечисленным факторам надо учесть, что организм в детском возрасте реагирует чаще и быстрее на различные воздействия. Бег, подвижные игры, физическая нагрузка провоцируют повышение белых кровяных клеток. Они выполняют метаболическую функцию у новорождённых, и их высокий уровень будет весьма настораживающим;
- Во время беременности белые кровяные клетки защищают женщину и ребёнка, поэтому высокий уровень является физиологическим процессом. Однако, возможно, образование базофильного лейкоцитоза, при котором увеличивается образование базофилов. Белые кровяные тельца также стимулируют сократительную маточную функцию и предупреждают попадание инфекций;
- Формула лейкоцитов у мужчин стабильная в случае отсутствия занятий силовыми видами спорта, интенсивных мышечных работах. Эти факторы являются основной причиной высокого лейкоцитоза;
- Нарушенный лейкопоэз в костном мозге не связан с физиологическим воздействием, а является подтверждением наличия заболевания.
Физиологический лейкоцитоз обуславливается перераспределением в сосуды разных органов увеличенного количества белых клеток. Как правило, возникает во время беременности, родов, предменструального периода, приёма пищи, холодных и горячих ванн, физической работы. Также в течение дня курение способствует повышенному уровню лейкоцитов.
Патологическое возникновение лейкоцитоза весьма опасно и связано с такими заболеваниями, как пиелонефрит, пневмония, менингит, сепсис и многие другие. А также в связи с заболеваниями, поражающими клетки иммунной системы и вызывающими воспалительный процесс. Исключениями будут заболевания, которые протекают с лейкопенией (краснуха, брюшной тиф, вирусный гепатит, корь, бруцеллёз, малярия в острой фазе). Высокий лейкоцитоз свидетельствует о борьбе организма, в обратном случае это будет свидетельствовать о неблагоприятном исходе.
Также развитие лейкоцитоза провоцируют воспалительные процессы немикробной этиологии, различные инфаркты, в основе которых лежит асептическое воспаление, кровопотери, ожоги, злокачественные образования. Исключением будут лишь метастазы в костном мозге, вследствие чего нарушается кроветворение и образуется лейкопения. Также уремия, диабетическая кома и удалённая селезёнка способствуют развитию патологической формы заболевания.
Кратковременный лейкоцитоз может возникнуть в процессе выброса лейкоцитов в кровь (стресс, переохлаждение). Реактивный лейкоцитоз может исчезнуть вместе с причиной его образования.
При наличии неспецифического язвенного колита, микседемы, хронического миелоидного лейкоза и беременности, довольно часто встречается базофильный лейкоцитоз, однако, это редкий клинико-гематологический синдром. При наличии хронической формы миелолейкоза, повышенный уровень базофилов свидетельствует о неблагоприятных признаках.
При наличии коклюша, вирусного гепатита, инфекционного мононуклеоза, туберкулёза, саркоидоза, сифилиса и других специфических инфекций, обнаруживается лимфоцитарный лейкоцитоз. Его механизм действия полностью неизвестен. Повышенное количество лимфоцитов, которые определяются по лейкоцитограмме, являются неистинными, а относительными и связаны с лейкопенией.
О начале септического процесса будет свидетельствовать моноцитарный лейкоцитоз. Как правило, это форма проявляется у пациентов имеющих туберкулёз, бруцеллёз, малярию, сыпной тиф, рак яичников и молочной железы, саркоидоз, инфекционный мононуклеоз, системное заболевание соединительной ткани, септический эндокардит.
Наблюдается повышенный уровень моноцитов у больных с агранулоцитозом на этапе выздоровления. Стабильно повышенный уровень моноцитов характерен при моноцитарном и миеломоноцитарном лейкозе. При наличии агранулоцитоза, повышение моноцитов будет свидетельствовать о начале регенерации кровотечения.
|
|
Патогенез
Нейрофильный лейкоцитоз сопровождается увеличенным образованием и выходом нейтрофилов в кровь, при котором увеличенное количество лейкоцитов отмечается в сосудистом русле. Подобное состояние можно наблюдать при острых инфекциях, хронических воспалениях, заболеваниях крови. При наличии острого инфекционного заболевания происходит ускоренный выход нейтрофилов из костного мозга.
Также не исключено развитие болезни вследствие продолжительного лечения лекарственными препаратами. При наличии этой формы заболевания необходимо ограничить себя от физических нагрузок, стрессовых ситуаций, перевозбуждения, так как в этом случае нейтрофилы только увеличатся. Различают два вида заболевания: патологический и физиологический нейтрофильный лейкоцитоз.
Истинным называется нейтрофильный лейкоцитоз, вызванный многими заболеваниями. Его проявление более стойкое и длительность течения зависит от формы, тяжести, природы и течения болезни. Наличие в периферической крови лейкоцитов бластных и юных форм будет свидетельствовать о тяжёлом течении заболевания.
Наличие эндо- и экзогенных интоксикаций, бактериальных и воспалительных заболеваний чаще всего сопровождается истинным нейтрофильным лейкоцитозом. В случае интоксикации лейкоциты проявляются токсической зернистостью.
Различают следующие типы нейтрофильного лейкоцитоза:
- регенераторный, при котором пропорционально увеличиваются разные формы гранулоцитарных лейкоцитов, выходящих в метамиелоцитовый кровоток;
- дегенеративный, при котором наблюдается повышенное содержание палочко-ядерных с дистрофическими изменениями клеток, которые характеризуются уменьшением количества сегментно-ядерных лейкоцитов. Также заболевание может возникнуть у больных, страдающих от кислородного голодания, при значительных потерях крови, при наличии острого гемолиза.
При диагностике лейкоцитоза в первую очередь проводится исследование крови для точного определения количества лейкоцитов, а также выявления причин, вызвавших данное состояние. В некоторых случаях берётся мазок периферической крови и проводится биопсия костного мозга. Для корректного подбора лечения специалист проводит полное диагностирование.
В случае пониженного уровня лейкоцитов, лабораторный анализ крови следует проводить три раза. Необходимо не просто узнать общее количество лейкоцитов, а знать точное количество каждого вида индивидуально. Подсчитывается лейкоцитарная формула.
Также не исключено развитие болезни вследствие продолжительного лечения лекарственными препаратами. При наличии этой формы заболевания необходимо ограничить себя от физических нагрузок, стрессовых ситуаций, перевозбуждения, так как в этом случае нейтрофилы только увеличатся. Различают два вида заболевания: патологический и физиологический нейтрофильный лейкоцитоз.
Истинным называется нейтрофильный лейкоцитоз, вызванный многими заболеваниями. Его проявление более стойкое и длительность течения зависит от формы, тяжести, природы и течения болезни. Наличие в периферической крови лейкоцитов бластных и юных форм будет свидетельствовать о тяжёлом течении заболевания.
Наличие эндо- и экзогенных интоксикаций, бактериальных и воспалительных заболеваний чаще всего сопровождается истинным нейтрофильным лейкоцитозом. В случае интоксикации лейкоциты проявляются токсической зернистостью.
Различают следующие типы нейтрофильного лейкоцитоза:
- регенераторный, при котором пропорционально увеличиваются разные формы гранулоцитарных лейкоцитов, выходящих в метамиелоцитовый кровоток;
- дегенеративный, при котором наблюдается повышенное содержание палочко-ядерных с дистрофическими изменениями клеток, которые характеризуются уменьшением количества сегментно-ядерных лейкоцитов. Также заболевание может возникнуть у больных, страдающих от кислородного голодания, при значительных потерях крови, при наличии острого гемолиза.
При диагностике лейкоцитоза в первую очередь проводится исследование крови для точного определения количества лейкоцитов, а также выявления причин, вызвавших данное состояние. В некоторых случаях берётся мазок периферической крови и проводится биопсия костного мозга. Для корректного подбора лечения специалист проводит полное диагностирование.
В случае пониженного уровня лейкоцитов, лабораторный анализ крови следует проводить три раза. Необходимо не просто узнать общее количество лейкоцитов, а знать точное количество каждого вида индивидуально. Подсчитывается лейкоцитарная формула.
Клиническая картина
Лейкоцитоз не является самостоятельным заболеванием и по этой причине симптомы указывают на болезни, которые способствовали его развитию. У детей зачастую симптомы отсутствуют и по этой причине нужен постоянный контроль кровяного состава. Это позволит обнаружить лейкоцитоз на ранней стадии развития. У взрослых обычно бессимптомное проявление заболевания.
Самый опасный вид лейкоцитоза, который встречается довольно редко - рак крови или лейкоз. Для того чтобы не упустить начало развития, необходимо знать симптомы. Самыми распространёнными являются:
- вялость, усталость, слабость, недомогание, которое возникает без причин;
- усиливается потоотделение в ночное время и повышается температура тела;
- часто образуются кровоподтёки, синяки, возникают спонтанные кровоизлияния;
- головокружение, обморочные состояния;
- болевые ощущения в брюшной полости, верхних и нижних конечностях;
- дыхание становится затруднительным и появляется одышка;
- снижается аппетит;
- нарушается зрение;
- необъяснимо снижается вес.
При обнаружении более двух вышеперечисленных симптомов необходимо не замедляя обратиться к специалисту и сдать анализ крови.
Как правило, в случае возникновения лейкопении (пониженный уровень лейкоцитов) заболевание сопровождают ярко выраженные симптомы. Организм постепенно начинает ослабевать, снижается иммунитет. Вследствие чего организм более уязвим к различным инфекционным заболеваниям.
Признаки, указывающие на распространение инфекционного заболевания: слабость, повышение температуры тела, пульс становится учащённым, появляется озноб. Далее, могут возникнуть воспалительные процессы в ротовой полости, в кишечнике появляются язвочки, железы опухают, селезёнка и миндалины будут увеличены в размерах. Наличие тех или иных симптомов будет зависеть от того, каких именно лейкоцитов не хватает. Лейкоцитоз влияет на общее состояние больного. Запущенная форма приводит к летальному исходу. Также вдвое увеличивается риск возникновения злокачественного новообразования.
Самый опасный вид лейкоцитоза, который встречается довольно редко - рак крови или лейкоз. Для того чтобы не упустить начало развития, необходимо знать симптомы. Самыми распространёнными являются:
- вялость, усталость, слабость, недомогание, которое возникает без причин;
- усиливается потоотделение в ночное время и повышается температура тела;
- часто образуются кровоподтёки, синяки, возникают спонтанные кровоизлияния;
- головокружение, обморочные состояния;
- болевые ощущения в брюшной полости, верхних и нижних конечностях;
- дыхание становится затруднительным и появляется одышка;
- снижается аппетит;
- нарушается зрение;
- необъяснимо снижается вес.
При обнаружении более двух вышеперечисленных симптомов необходимо не замедляя обратиться к специалисту и сдать анализ крови.
Как правило, в случае возникновения лейкопении (пониженный уровень лейкоцитов) заболевание сопровождают ярко выраженные симптомы. Организм постепенно начинает ослабевать, снижается иммунитет. Вследствие чего организм более уязвим к различным инфекционным заболеваниям.
Признаки, указывающие на распространение инфекционного заболевания: слабость, повышение температуры тела, пульс становится учащённым, появляется озноб. Далее, могут возникнуть воспалительные процессы в ротовой полости, в кишечнике появляются язвочки, железы опухают, селезёнка и миндалины будут увеличены в размерах. Наличие тех или иных симптомов будет зависеть от того, каких именно лейкоцитов не хватает. Лейкоцитоз влияет на общее состояние больного. Запущенная форма приводит к летальному исходу. Также вдвое увеличивается риск возникновения злокачественного новообразования.
Лечение
Лечение лейкоцитоза основано на симптомах и анамнезе пациента.
Лейкоцитоз у новорождённых включает в себя лечение основного инфекционного заболевания с назначением антибиотиков. Хотя встречаются случаи, когда детский организм начинает реагировать на лечение, уменьшая симптоматику, таким образом, вернуть лейкоциты к нормальным показателям немного труднее. При простудном заболевании следует своевременно начать лечение непосредственно этого заболевания, и лейкоциты нормализуются самостоятельно спустя определённое время.
Можно одновременно с грамотным медикаментозным лечением лечить лейкоцитоз народными средствами. Наиболее эффективным методом является отвар из ягод брусники и ее листьев. Например, одна ложка ягод и листьев заливается кипятком и на протяжении 15 минут кипятится. Затем полученный отвар необходимо процедить. Рекомендовано пить не более трёх раз в день. Также можно заваривать почки берёзы белой, на протяжении 30 минут из расчёта на один стакан воды одна столовая ложка. Принимается отвар не более четырёх раз в день. Отвар из ягод земляники и листьев необходимо залить кипятком и варить не больше 5 минут. Все отвары оказывают положительный эффект на общее состояние при лейкоцитозе.
Метод лечения лейкоцитоза полностью зависит от заболевания, которое сопутствовало его возникновению. Курс медикаментозной терапии будет назначен после полноценно проведённой диагностики. Назначенные антибиотики направлены на излечение и предотвращение инфекции, а также для предотвращения развития сепсиса. Для уменьшения или снятия воспалительного процесса назначаются стероиды, уменьшающие уровень лейкоцитов. Для того чтобы снизить в моче уровень кислоты, назначаются антациды. В случае наличия аллергической реакции, возможно назначение антигистаминных лекарственных препаратов.
В редких случаях проводится извлечение избыточных лейкоцитов с помощью лейкафереза. Концентрат лейкоцитов, который был получен в результате процедуры, врачи или доставят донорскому центру, или будут обратно вливать больному. Также могут быть назначены препараты, направленные на предотвращение разрушения тканей, которые лейкоцитоз провоцирует.
Если выявлен лейкоцитоз во время беременности, специалисты назначают лечение, направленное на устранение причины его возникновения. В случае наличия инфекционного заболевания и неэффективности лечения уже прописанными лекарственными препаратами, будут назначены антибиотики, соответствующие сроку беременности без вреда для ребёнка. Препараты подбираются для каждой женщины индивидуально, учитывая чувствительность возбудителя к лекарствам. Если возбудителя определить не удалось, то лечение не даст никаких результатов. В случае правильного лечения и точно выполненных рекомендаций, женщина сможет защитить не только себя, но и ребёнка. В этом случае категорически запрещено использование народных средств.
Также необходимо учитывать, что отказ от лекарственных препаратов во время беременности может спровоцировать продолжительные воспалительные процессы, которые приведут к серьёзным последствиям. Заболевание, которое будет прогрессировать в организме будущей мамы, способно прервать беременность или создать осложнения. Именно по этой причине лечение лейкоцитоза беременных женщин крайне важно.
Важным этапом в процессе лечения является правильное индивидуальное питание. В случае пониженного уровня лейкоцитов, питание должно быть обогащено продуктами, стимулирующими выработку гемоглобина. Лучше всего употреблять продукты, обогащённые витамином В9, бобовые, пить молоко. Также следует ограничить употребление мясных продуктов, полностью исключив почки и печень.
Лейкоцитоз у новорождённых включает в себя лечение основного инфекционного заболевания с назначением антибиотиков. Хотя встречаются случаи, когда детский организм начинает реагировать на лечение, уменьшая симптоматику, таким образом, вернуть лейкоциты к нормальным показателям немного труднее. При простудном заболевании следует своевременно начать лечение непосредственно этого заболевания, и лейкоциты нормализуются самостоятельно спустя определённое время.
Можно одновременно с грамотным медикаментозным лечением лечить лейкоцитоз народными средствами. Наиболее эффективным методом является отвар из ягод брусники и ее листьев. Например, одна ложка ягод и листьев заливается кипятком и на протяжении 15 минут кипятится. Затем полученный отвар необходимо процедить. Рекомендовано пить не более трёх раз в день. Также можно заваривать почки берёзы белой, на протяжении 30 минут из расчёта на один стакан воды одна столовая ложка. Принимается отвар не более четырёх раз в день. Отвар из ягод земляники и листьев необходимо залить кипятком и варить не больше 5 минут. Все отвары оказывают положительный эффект на общее состояние при лейкоцитозе.
Метод лечения лейкоцитоза полностью зависит от заболевания, которое сопутствовало его возникновению. Курс медикаментозной терапии будет назначен после полноценно проведённой диагностики. Назначенные антибиотики направлены на излечение и предотвращение инфекции, а также для предотвращения развития сепсиса. Для уменьшения или снятия воспалительного процесса назначаются стероиды, уменьшающие уровень лейкоцитов. Для того чтобы снизить в моче уровень кислоты, назначаются антациды. В случае наличия аллергической реакции, возможно назначение антигистаминных лекарственных препаратов.
В редких случаях проводится извлечение избыточных лейкоцитов с помощью лейкафереза. Концентрат лейкоцитов, который был получен в результате процедуры, врачи или доставят донорскому центру, или будут обратно вливать больному. Также могут быть назначены препараты, направленные на предотвращение разрушения тканей, которые лейкоцитоз провоцирует.
Если выявлен лейкоцитоз во время беременности, специалисты назначают лечение, направленное на устранение причины его возникновения. В случае наличия инфекционного заболевания и неэффективности лечения уже прописанными лекарственными препаратами, будут назначены антибиотики, соответствующие сроку беременности без вреда для ребёнка. Препараты подбираются для каждой женщины индивидуально, учитывая чувствительность возбудителя к лекарствам. Если возбудителя определить не удалось, то лечение не даст никаких результатов. В случае правильного лечения и точно выполненных рекомендаций, женщина сможет защитить не только себя, но и ребёнка. В этом случае категорически запрещено использование народных средств.
Также необходимо учитывать, что отказ от лекарственных препаратов во время беременности может спровоцировать продолжительные воспалительные процессы, которые приведут к серьёзным последствиям. Заболевание, которое будет прогрессировать в организме будущей мамы, способно прервать беременность или создать осложнения. Именно по этой причине лечение лейкоцитоза беременных женщин крайне важно.
Важным этапом в процессе лечения является правильное индивидуальное питание. В случае пониженного уровня лейкоцитов, питание должно быть обогащено продуктами, стимулирующими выработку гемоглобина. Лучше всего употреблять продукты, обогащённые витамином В9, бобовые, пить молоко. Также следует ограничить употребление мясных продуктов, полностью исключив почки и печень.